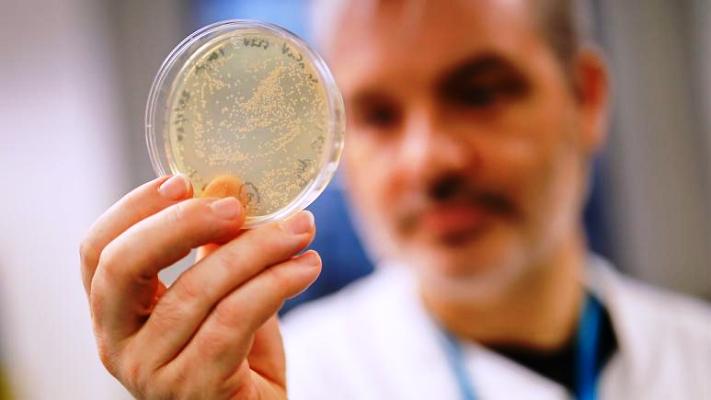

*Covid-19 raporu: 11 Avrupa ülkesi mercek altına alındı; Belçika’da önlemler 560 hayat kurtardı
İngiltere’de Imperial College London, koronavirüs ile mücadele kapsamında 11 Avrupa ülkesini mercek altına aldı.
Araştırmaya göre Belçika’da, hükümetin aldığı önlemler sayesinde en az 560 kişinin hayatının kurtulduğu tespit edildi. Tahminlerin durum değişikliğinden dolayı 160 ila bin 500 kişi arasında olabileceği belirtiliyor.
Raporda 28 Mart tarihinde, Belçika’da halkın yüzde 3,7’sinin koronavirüse yakalanmış olabileceğini öne sürüyor. Bu rakamların İtalya’da yüzde 9,8, İspanya’da ise yüzde 15 olduğu belirtiliyor.
Daha düşük vaka sayısına sahip Almanya’da ise bu oran yüzde 0,41 ve Norveç için ise 0,72 olarak belirtiliyor.
Araştırma hangi ülkenin ne zaman önlem almaya başladığına da ışık tutuyor. Buna göre İtalya ve İspanya’nın 9 Mart’ta vatandaşlar arasında mesafe kurulmasını talep ettiği görülüyor. İsviçre ise karantina önlemleri alan ilk ülke olduğu belirtiliyor.
Diğer alınan önlemler arasında etkinliklerin iptal edilmesi, okulların kapatılması ve evden çıkışların sınırlandırılması bulunuyor.
Araştırma özellikle Avusturya, Belçika, Danimarka, Fransa, Almanya, İtalya, Norveç, İspanya, İsveç, İsviçre ve İngiltere’ye odaklandı.
‘ALINAN ÖNLEMLERE RAĞMEN 1,8 MİLYON KİŞİ ÖLEBİLİR’
Geçtiğimiz hafta aynı üniversite dünya genelinde alınan önlemlere rağmen koronavirüs (Covid-19) salgınının 1,8 milyon kişinin ölümüne neden olabileceğini duyurmuştu.
Aynı kurum Mart ayı ortasında yayımladığı bir önceki raporda ise İngiltere’de halkın yüzde 81’inin koronavirüse yakalanabileceğini, 510 bin kişini ölebileceğini öne sürmüştü. Raporda kullanılan yöntemler bilim insanları tarafından eleştirildi ancak hükümet salgına karşı stratejisini değiştirerek önlemleri artırma kararı almıştı.
Araştırmacılar dünyada hiç bir önlem alınmaması durumunda 40,6 milyon kişinin ölebileceğini, 7 milyar kişinin ise koronavirüse yakalanabileceğini belirtiyor.
Imperial College London’da yapılan araştırmalar hastalıkla ilgili uzmanların elinde bulunan bilgilere dayanarak tahminden ibaret olduğu belirtiliyor.
(Euronews / Foto:AFP)